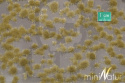
Tuft - Krótka późnojesienna trawa (15x4 cm)

-
Koszyk jest pusty
-
x
Do bezpłatnej dostawy brakuje
-,--
Darmowa dostawa!
Suma
0,00 zł
Cena uwzględnia rabaty

0,00 zł
0
-
Koszyk jest pusty
-
x
Do bezpłatnej dostawy brakuje
-,--
Darmowa dostawa!
Suma
0,00 zł
Cena uwzględnia rabaty
-
Tuft - Krótka późnojesienna trawa (15x4 cm)




Symbol:
SIL717-24S
26.29
| Wysyłka w ciągu | 24 godziny |
| Cena przesyłki | 11.99 |
| Dostępność |
|
| Kod kreskowy | |
| EAN | 4048847617247 |
Tuft - Krótka późnojesienna trawa (15x4 cm)
-
Zestaw akcesoriów, które idealnie urozmaicą każdą scenerię. Te drobne detale sprawdzą się zarówno w dekoracji pojedynczych podstawek na figurki, jak i całych makiet, dioram i pól bitew.
Kępki należy oderwać od folii i przykleić na podstawkę, makietę
Dane producenta
Silhouette Modellbau GmbH
Buschingstrasse 5
82216 Maisach - Gernlinden
Germany
+49081426526611
info@mininatur.de
Nie ma jeszcze komentarzy ani ocen dla tego produktu.
- Producenci